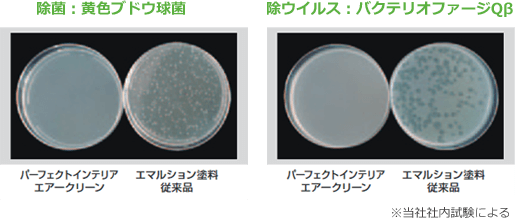
image

リバウスの室内塗装では、を使用するから安心して毎日を過ごすことができます。さらに、超低臭で消臭機能もあり、空浮きをキレイにします。

![]()
リバウスでは、パーフェクトインテリアエアクリーンというを使用します。
また、塗料中に揮発性有機化合物(VOC)をほとんど含まず、超低臭・消臭機能つき。
を使用します。
PIAJ製品認証取得
PIAJ製品認証とは、光触媒工業会が、性能、利用方法等が適切であることを認めた光触媒製品に与える製品認証です。
所定の試験機関にて、性能判定基準を満足する、製品の品質・性能に対する信頼の証です。
![]()
除ウイルス・除菌
可視光応答形光触媒により弱い室内の照明でも反応し、菌やウイルスの繁殖を抑制します。
※抗菌性:黄色ブドウ球菌、抗ウイルス性:バクテリオ
ファージQβでの試験結果に基づいています。
従来の光触媒
(紫外光応答形光触媒)
従来の光触媒(紫外光応答形 )は 、太陽光などの強い光の照射下で作用しますが、室内光では作用し難く、菌やウイルスの繁殖抑制効果が小さい。

パーフェクトインテリア
エアークリーン
(可視光応答形光触媒)
可視光応答形光触媒が、弱い室内の照明でも光励起し、除菌・除ウイルス作用を発現し 、ニオイ・汚れなどの原因となる菌や有害なウイルスの繁殖を抑制します。

※本製品は、医療品や医療機器などの医療を目的としたものではありません。
また、本製品は表面に付着したウイルスを抑制するものであり、感染予防を保証するものではありません。

※当社社内試験による

※当社社内試験による
![]()
超低臭気
特殊エマルションの採用により、従来の低臭エマルション塗料よりもVOC含有量が極めて少なく、超低臭で、塗装中や塗装後も嫌な臭いが残りません。

※当社社内試験による
![]()
消臭性
特殊吸着材の働きにより室内の嫌な臭いを吸着。
常にクリーンな状態を保ちます。


※当社社内試験による

![]()
防藻・防かび性
防藻・防かび性があり、
かびなどの発生を防ぎます。

![]()
汚染物質吸着
クロスの接着剤や建具合板などから発生する室内汚染物質を化学的に吸着して、除去します。
